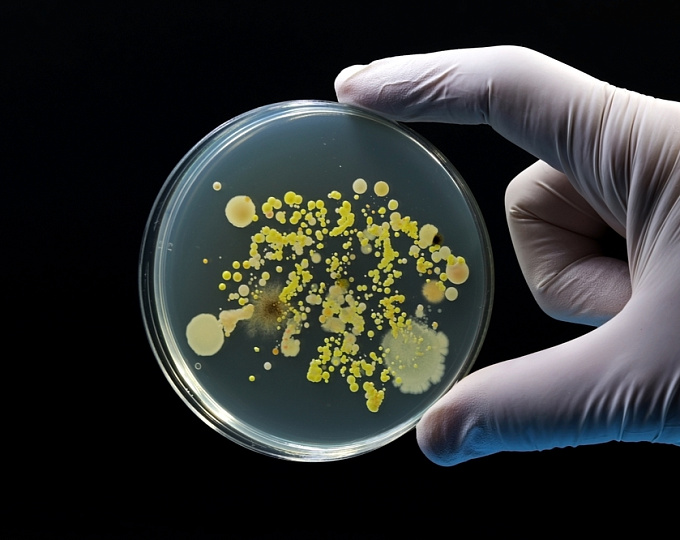
Какое влияние оказывает терапия рифампицином в высокой дозы на выживаемость у пациентов с туберкулезным менингитом?

Актуальность
Туберкулезный менингит представляет собой летальное заболевание, а у выживших ассоциирован с высокой частотой инвалидности несмотря на антимикробную терапию.
Целью исследования было оценить какое влияние оказывает терапия рифампицином в высокой дозы на выживаемость.
Дизайн исследования
HARVEST представляет собой двойное слепое рандомизированное плацебо-контролируемое клиническое исследование, участниками которого являлись пациенты с туберкулезным менингитом из Индонезии, Южной Африки и Уганды.
В качестве терапии пациенты получали изониазид, рифампицин (в дозе 10 мг/кг), этамбутол и пиразинамид + дополнительная доза рифампицина (кумулятивная доза 35 мг/кг) или плацебо на 8 недель. В обеих группах пациенты получали повторный курс терапии на 9 и 12 месяцах.
Результаты
- В исследование рандомизировали в отношении 1:1 499 пациентов.
- На протяжении 6 месяцев наблюдения 109 пациентов из группы высокодозовой терапии рифампицином (44,6%) и 100 пациентов из группы стандартной дозы рифампицина (40,7%) умерли (повышение риска на 17%, коэффициент рисков, 1,17; 95% доверительный интервал 0,89-1,54; P = 0,25).
- Среди умерших пациентов, среднее время до смерти составило 13 дней в группе рифампицина в высокой дозе, по сравнению с 24 днями в группе рифампицина в стандартной дозе.
- По данным анализа безопасности лекарственно-ассоциированное поражение печени отмечено у 8% среди пациентов, получающих высокую дозу рифампицина, по сравнению с 4,4% пациентов, получающих стандартную дозу рифампицина.
Заключение
Среди пациентов с туберкулезным менингитом не отмечено положительного клинического эффекта на фоне применения рифампицина в высокой дозе.
Источник: Meya DB, Cresswell FV, Dai B, et al for HARVEST Trial Team. Trial of High-Dose Oral Rifampin in Adults with Tuberculous Meningitis. N Engl J Med. 2025 Dec 18;393(24):2434-2446. doi: 10.1056/NEJMoa2502866.